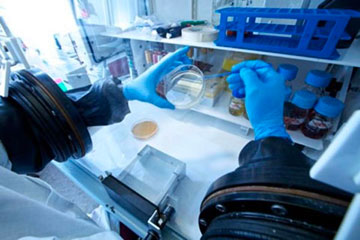
lab

La nostra mission: Studiare, diagnosticare e trattare le malattie allergiche basandosi su aggiornamenti continui e scambio interspecialistico.
Formare giovani medici specializzandi in Allergologia e Immunologia Clinica alla pratica professionale allergologica più rigorosa.
Allergy Update:
👉 notizie in 2 minuti